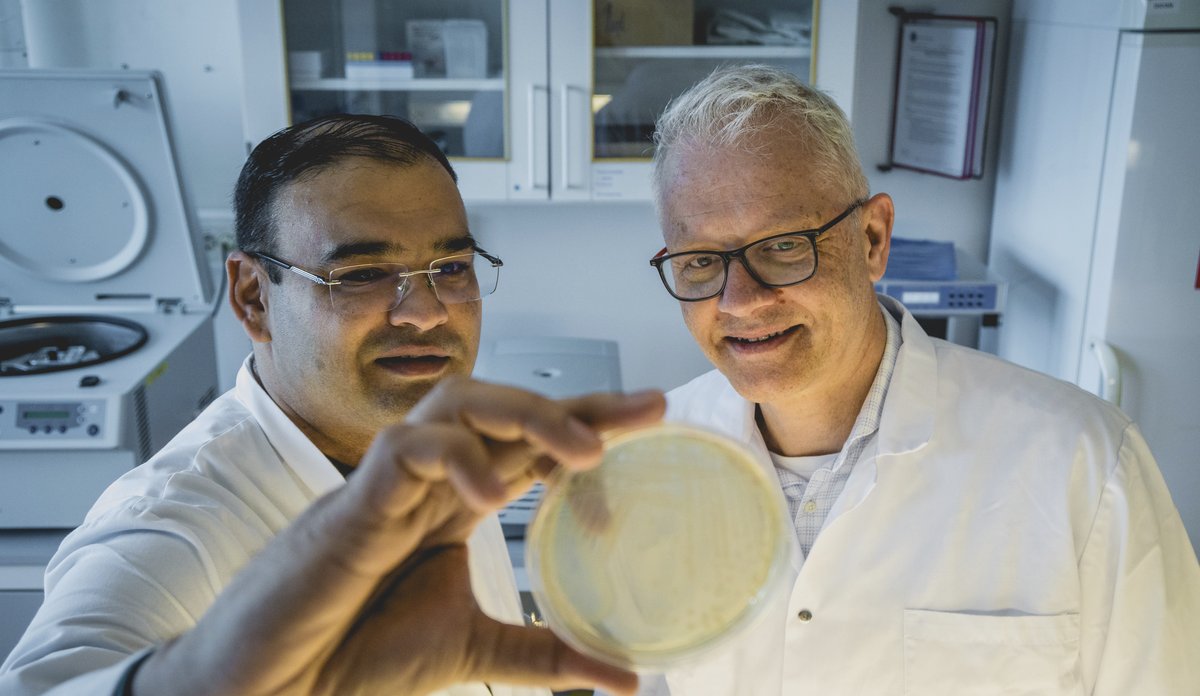
Two men looking a petridish

This newly discovered bacterium is named after IMR
The ocean is full of bacteria. For the first time, introducing: Pseudomonas imrae.
Photo: Erlend Astad Lorentzen / HIPublished: 26.05.2025 Updated: 28.05.2025
"I considered calling it “The Institute of Marine Research”, but then the name became too long," says marine scientist Nachiket Marathe and laughs.
He has recently described and thus named a completely new bacterium: Pseudomonas imrae.
The last part of the name is in honor of the Institute of Marine Research (IMR).
Found in mackerel
The newly discovered bacterium was found in stomach samples from mackerel, which were caught in the North Sea in November 2018.
IMR researcher Marathe is the first to have isolated and studied the bacterium.
"Within the bacterial world, we have a number of standardized methods that allow us to classify which bacteria we are dealing with. But this one didn’t quite fit anywhere – even though some of its gene sequences had over 90 percent overlap with other bacteria we know of."
This is quite typical for bacteria belonging to the genus Pseudomonas: they have a complicated taxonomy and can share many common features with each other, but still be something completely unique.
In other words, the bacterium was a blank slate, and that's when the work really starts.
Illustrasjonsfoto: Leif Nøttestad / Havforskingsinstituttet
"Our researches are making their mark"
Nils Gunnar Kvamstø, CEO of the Institute of Marine Research, is delighted with the newly named bacterium – both the name, but also the work that has gone into describing it for the first time.
"It’s a joy, watching our researchers excel and make their mark, both nationally and internationally. IMR aims to conduct world-leading marine research, and this shows us doing just that," says Kvamstø.
The ocean and its marine ecosystems are complex. Each organism plays a unique role – whether it is killer whales, herring, corals or microbes.
Bacteria have been found in the Mariana Trench – the deepest area of the ocean, at over 11,000 meters – under the ice in Antarctica and in sediment that is several hundred meters below the seabed. Most of them are harmless and necessary for a healthy and productive ocean.
"All links in the food chains and the ecosystem are interconnected and dependent on each other," says Kvamstø and continues:
"Therefore, it is important to also gain more knowledge about the smallest components – especially in a time where the oceans are under increasing pressures. Even the smallest microbe can play a big role."
An almost endless amount of unknown bacteria
The newly described P. imrae Marathe isolated in 2018. The years since have been spent performing a lot of different experiments in his spare time, between other projects.
"There is a colossal vault of unknown bacteria, especially in marine environments. But at HI we have the methods to isolate and describe them," says the marine scientist and continues:
"We are finding more and more new bacteria, and characterizing these is important – but it also takes time."
You cannot identify a bacterium based on how it looks, from differences and characteristics on the surface. The researchers are doing experiment after experiment:
"What substrates and sugars do the bacteria utilize? What other waste products does the bacterium produce? Does it produce acid or gas? Which fatty acids are present in them? What temperature does it thrive in? What salt concentration do they grow at? What do the DNA sequences look like? What about the entire genome? What antibiotics it is sensitive and resistant to?"
Nachiket Marathe goes through some of the research they have conducted to finally figure out what kind of bacterium this is and what properties it has.
"The list of experiments is almost endless," says the marine scientist.

Foto: Erlend Astad Lorentzen
Important, but often ignored
Describing bacteria can be tedious work, and it doesn't necessarily bring much honor and glory for the effort. Nevertheless, Nachiket Marathe is clear that he thinks it is meaningful work.
"When we characterize a bacterium, it helps us understand the role it has in the ecosystem."
The marine scientist points out that 70 to 90 percent of all biomass in the ocean is precisely microbes.
"There are more bacteria in the ocean than there are fish. These are a large part of the ecosystem: microbes break down dead organic matter, recycle nutrients and keep the ecosystem going, but they are always overlooked."
In the mackerel stomach – and his own stomach!
It's not just in the mackerel stomach that Nachiket Marathe has found unknown bacteria. He has actually found the same thing in his own stomach:
"As a doctoral student, I used samples from myself in a project we had. It was a bit too much fun, but I isolated new bacteria."
Marathe named the bacteria after his home country, India: Megasphaera indica.
He has previously characterized and named a new genus of bacteria isolated from patients with wound infection in Sweden after Scandinavia and the city of Gothenburg, Sweden: Scandinavium goeteborgense. He still has a few that he will introduce to the world, when time allows:
According to the marine scientist, the “book of all books” in microbiology is Bergey's Manual of Systematic Bacteriology.
"It's like our “bible”. When you have published a taxonomic description of a bacterium, it is added to the manual. Suddenly you are part of the bacterial bible."
